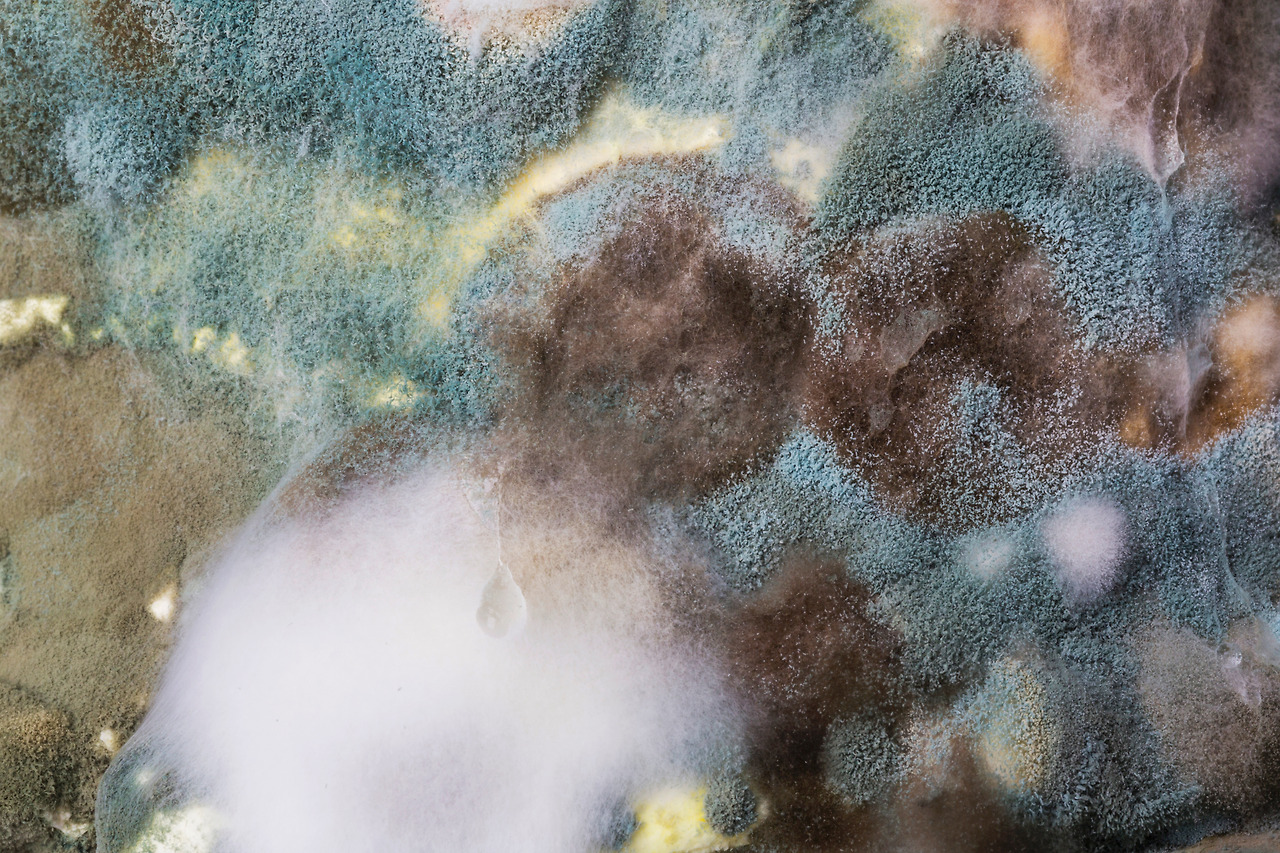
01.jpg

쉽고 효과적인 벽지 곰팡이 제거법 5가지
다가오는 장마철 공포

오래된 집에 습기가 차거나
세탁실이나, 베란다 벽을 타고 곰팡이가
불현듯 나타난 적이 있으실 텐데요!
그런 곰팡이 쉽게 지울 방법 없을까요?
함께 알아보아요~

1) 물에 젖은 걸레 등으로 문지르지 마세요!
물에 젖은 걸레나 수건으로 곰팡이를 제거하려는 행동은
절대 금물입니다!! 이런 행동은 곰팡이가 제거되긴
커녕 벽지에 쫙쫙 자국이 번진다는 사실~~!!

2) 반창고
벽지의 재질이 두껍고 튼튼하다면
스카치테이프도 나쁘지 않지만, 벽지의 손상을
최소화시키려면 반창고를 이용하는 것이 좋습니다.
우선 접착면이 바깥으로 오게끔 하여
손가락이나 손에 한 바퀴 감아주시고,
곰팡이 쪽에 두드려주면 곰팡이가 떼어져 나오면서
어느 정도 완화시킬 수 있습니다.
옅은 자국엔 괜찮은 방법입니다~

3) 락스
락스는 곰팡이가 있는 곳이라면 어디든지 효과 만점인
만능 아이템인데요! 락스를 바르거나 분무기로
분사시키면 시간이 경과한 뒤 곰팡이가 사라집니다!

4) 세탁세제
집안의 필수 아이템인 세탁세제로도
곰팡이를 어느 정도 제거할 수 있는데요.
세탁세제 풀어놓은 물을 분사시킨 뒤 살살 문질러주세요!
제거가 끝나면 마른걸레로 닦아주시고
선풍기나 헤어드라이기로
벽을 충분히 건조하여주는 것이 중요합니다!

5) 방습지 붙이기
곰팡이가 핀 벽에 방습지를 붙여주면
곰팡이가 베어 나옴을 억제해주고,
습기도 막아줍니다. 비슷한 방법으로
단열재를 붙여서 다시 시공하는 방법도 있죠!

사실 벽지 곰팡이를 제거하는 방법은
굉장히 한정적인데요~
락스로 제거하는 게 가장 효과적이고
재시공을 할 경우 단열재 등을
이용하여 재발을 막아주세요~
↓유용한 인테리어 정보 & 생활정보 보러 가기↓